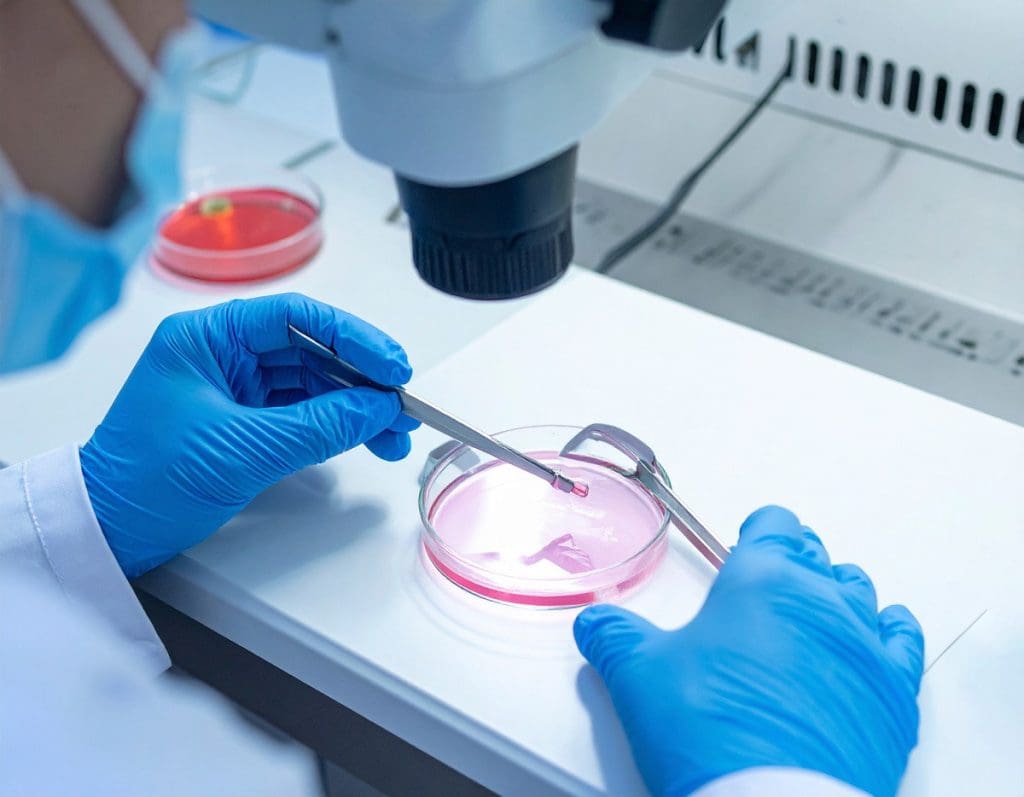

Photo: David Møbjerg Kristensen. Credit: Roskilde University.
For decades, paracetamol has been regarded as a safe option for treatment of pain and fever during pregnancy. But a new landmark study titled Paracetamol (N-acetyl-para-aminophenol) disrupts early embryogenesis by cell cycle inhibition (Human Reproduction, August 2025) reveals that paracetamol inhibits a key enzyme necessary for DNA replication (the body’s ability to copy its genetic material), thereby halting cell division in early embryos. Alongside clinical findings and animal studies, the results might point to a stronger link between paracetamol use and reproductive health risks than previously recognised.
– This is the first time we have shown that paracetamol directly impairs DNA replication in the early embryo, says David Møbjerg Kristensen, who led the study and serves on the DDEA Committee for Education.

Photo: Paracetamol. Credit: Canva
Paracetamol interferes with DNA replication by inhibiting a small enzyme that cells rely on to construct DNA. The 2025 study identifies ribonucleotide reductase (RNR) as a molecular target of paracetamol. RNR is essential for converting ribonucleotides to deoxyribonucleotides – the building blocks of DNA – in the eukaryotic cell. Without it, cells cannot divide.
Using of experimental models ranging from yeast to human embryonic stem cells and embryos, the researchers demonstrated that paracetamol inhibits RNR, causing cell cycle arrest during the earliest stages of development.
– DNA synthesis is critical for all life. Therefore, if a substance interferes with that process, it strikes at something truly fundamental for development. And that’s exactly what we saw, Kristensen explains.

Photo: DNA. Credit: Canva.
Between 10 and 40% of pregnancies fail around the time of implantation (when the fertilised egg attaches to the womb). Roughly, half of these early losses can be explained by genetic abnormalities – errors in the embryo’s DNA. Lifestyle factors such as smoking and alcohol are also known contributors.
Yet a significant proportion remains unexplained. This study suggests that paracetamol may be part of the missing explanation by altering the body’s chemical environment within the women.
By interfering with DNA replication, paracetamol may reduce the chances of successful implantation or lead to early pregnancy loss before implantation. Hence, the study investigated effects of paracetamol exposure during the first few days after conception, when the fertilised egg undergoes rapid, tightly coordinated cell divisions. In this way, the study highlights how critical chemical exposure can be during these early days in development.

Photo: Negative pregnancy test. Credit: Canva.
The effects go beyond embryonic development. In a 2024 clinical study published in Cephalalgia, Kristensen and colleagues examined women suffering from medication-overuse headache – a group exposed to high doses of paracetamol due to dependence of pain medications such as paracetamol.
These women had significantly lower levels of Anti-Müllerian Hormone (AMH) – a key biomarker for ovarian reserve (how many eggs a woman has), often measured early during fertility assessments.
– In the study, we found that paracetamol disrupts the cells that produce AMH, called granulosa cells, in a similar way to what we found in the early embryo. This suggests that a compound such as paracetamol can affect female fertility both during the early phase of pregnancy and in adult women by disrupting critical endocrine cells, says Kristensen.
Photo: Fertility lab with a scientist handling a petri dish under a mic. Credit: Canva
The reason that Kristensen and co-workers initially got interested in cell division was due to studies performed in rodent models. In these studies, they found that after exposure during fetal life, paracetamol exposure led to a 50% reduction in ovarian egg count in the adult animals. The data suggested that this reduction was due to an inhibition in proliferation of the cells within the developing ovary.
– We need to remember that paracetamol is still an important medication. But our data also suggest that many do not regard it as real medication. It is real medication with real side effects, says Professor David Møbjerg Kristensen
Paracetamol’s effects on fertility are not limited to women. Previous studies by Kristensen and colleagues have shown that the drug lowers testosterone levels in male foetuses and interferes with normal testicular development.
– During foetal development, the testicles need to descend into the scrotum – a process driven by testosterone. Our studies suggest that paracetamol can interfere with this hormone-driven signal, disrupting testicular descent, Kristensen explains.
Maldescent into the scrotum of testicles is a condition termed cryptorchidism, and children born with this disorder have a higher risk on fertility problems and testicular cancer in adult life.
In adult men, paracetamol has also been found to accumulate in seminal fluid (semen). Once inside the body, it is metabolised – broken down into various chemical compounds – some of which appear to impair sperm function by disrupting CatSper ion channels. These channels serve as the microscopic navigation system that helps sperm reach the egg.
In short, paracetamol might disturb the sperm’s internal compass, reducing its ability to find its target.

Photo: A detailed 3D-rendered image of sperm cells approaching an egg cell in a microscopic biological reproduction process. Credit: Canva
Kristensen’s group is now exploring whether paracetamol’s side effects could extend to brain development together with national and international colleagues. Several epidemiological studies have reported associations between prenatal paracetamol exposure and neurodevelopmental outcomes such as ADHD.
Although the evidence is still debated, Kristensen and colleagues now believe that the same mechanism – interference with DNA replication – could help explain these associations.

Photo: David Møbjerg Kristensen in the lab. Credit: Rigshospitalet.
To investigate further, the group has received funding from the Lundbeck Foundation and is collaborating with Harvard Medical School, Harvard School of Public Health together with teams from Gentofte and Glostrup hospitals working with COPSYCH cohort. Their goal is to determine whether the disruption of DNA replication seen in embryos might also underlie the neurodevelopmental effects observed in population-based data.
Paracetamol is one of the most widely used drugs in Denmark – available over the counter in supermarkets, often placed just below the chewing gum.
– It’s sold next to the sweets in supermarkets, and that might send a signal. People forget that this is real medicine, with real effects and real side effects, says Kristensen.
In fact, Danes consume over one billion paracetamol tablets each year – which translates to around 181 tablets per person annually or nearly 1 tablet every other day.
While the drug continues to play a vital role in healthcare, Kristensen emphasises the need to acknowledge its potential side effects during sensitive developmental windows as early pregnancy. As the research indicates, even the doses found in the women after standard use of 1 gram (one tablet of paracetamol is 500 mg) may interfere with essential cellular processes such as DNA replication, with possible consequences for fertility and embryonic development.
Kristensen and colleagues are now pursuing three major research directions:
Falling birth rates and increasing concern about chemical exposure make these findings especially timely. The study has already attracted significant media attention in Denmark.
– Paracetamol is something nearly everyone has taken. And declining fertility rates are now a matter of national policy, even addressed by the Prime Minister in her New Year’s speech. So, we might have struck a sensitive nerve, Kristensen reflects.
For more on the findings, you can listen to the DR podcast Genstart, the episode titled ‘En bitter pille’ (in Danish).

Photo: David Møbjerg Kristensen. Credit: Roskilde University.
David Møbjerg Kristensen is Professor of Molecular Physiology at Roskilde University and Senior Scientist at Copenhagen University Hospital – Rigshospitalet. He is also affiliated with Inserm – the French National Institute of Health and Medical Research – where he has worked extensively to investigate how over-the-counter medications such as mild analgesics can disrupt foetal development and adult endocrinology.
His scientific interests focus on human development and endocrinology, with a particular emphasis on how these processes are affected by the chemical environment – especially concerning fertility and brain development.
David Kristensen is a member of DDEA Committee for Education. He is also co-organising three DDEA education and networking activities: Role of Ageing in Health and Disease with a Focus on Endocrinology on 23-25 September in Odense, Ultraprocessed Foods Networking Meeting on 5-6 March 2026 in Aarhus and Sex Hormones and the Brain Nov 2026.
EAN: 5798 0022 30642
Reference: 1025 0006
CVR: 29 19 09 09